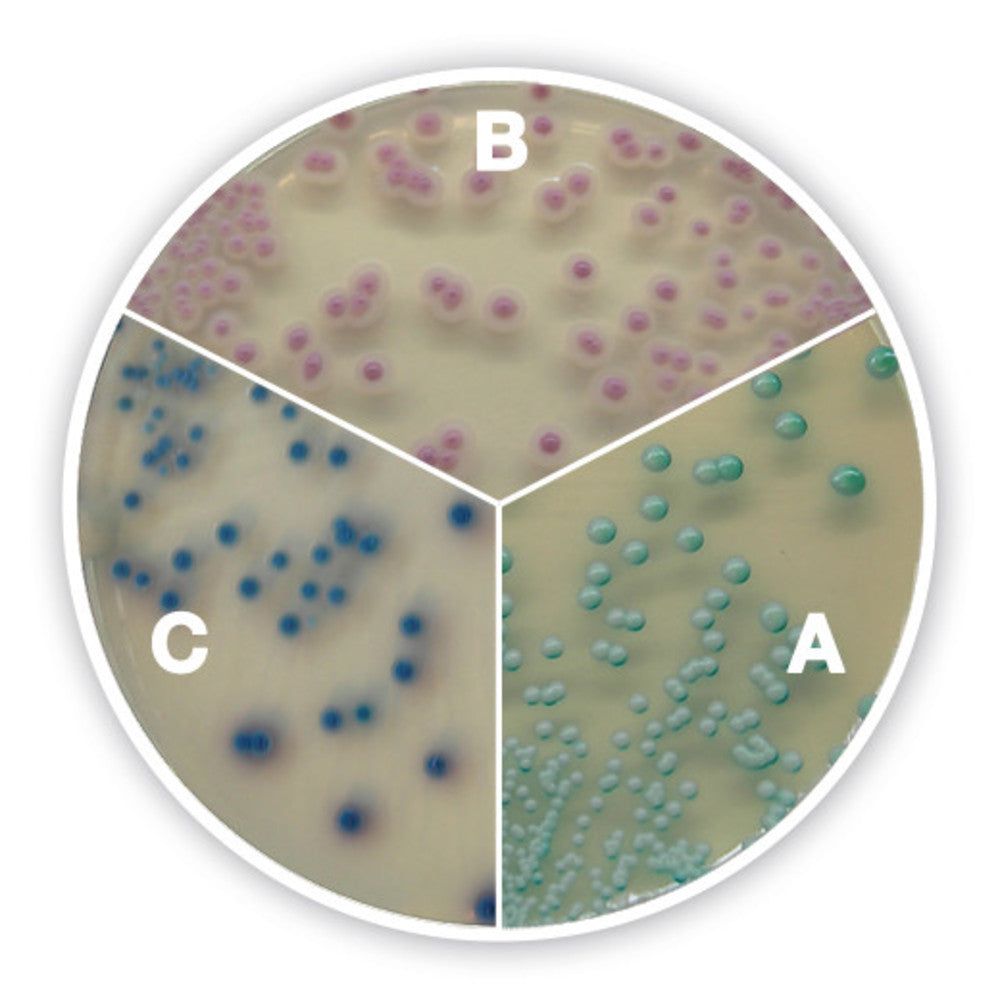
Image of Candida chromogenic Agar plus

Categories
L-Glutamic acid
Depuis €16,12
Bovine Serum Albumin (BSA) Fraction V
Depuis €23,98
Bovine Serum Albumin (BSA) Fraction V
Depuis €28,31
FreezeCell cryo-freezing device hexagon
Depuis €138,47
FreezeCell cryo-freezing device, rectang
Depuis €138,47
ROTI®Cell Freezing Medium, serum free
Depuis €187,24
Geneticin disulphate (G<sub>418</sub>)-solution
Depuis €67,84
Gentamycin sulphate solution
Depuis €103,64
CASO Broth vegetal
Depuis €94,93
Egg Yolk Tellurite Emulsion (20 %)
Depuis €58,81
Egg Yolk Emulsion (20 %), ISO 7932
Depuis €49,21
MacConkey Agar, granulated
Depuis €155,89
Orange Serum Agar, granulated
Depuis €265,60
Yeast Glucose Agar,with chloramphenicol
Depuis €248,18
Liquid extraction station
Depuis €952,61
Candida chromogenic Agar plus
Depuis €178,52
ROTI®Cell DMEM : F<sub>12</sub>
Depuis €17,87
VAS-ECO extraction system
Depuis €565,99
VAS-10 extraction system
Depuis €1.078,88
Plate Count Agar, granulated
Depuis €195,94
R<sub>2</sub>A-Agar, granulated
Depuis €239,48
Violet Red Bile Agar with Glucose,
Depuis €199,42
Maximum Recovery Solution
Depuis €31,80
Letheen Broth modified
Depuis €46,94
Fraser Half Broth
Depuis €41,72
Peptone Water, buffered
Depuis €37,39
ROTI®ContiPlate VRB
Depuis €80,92